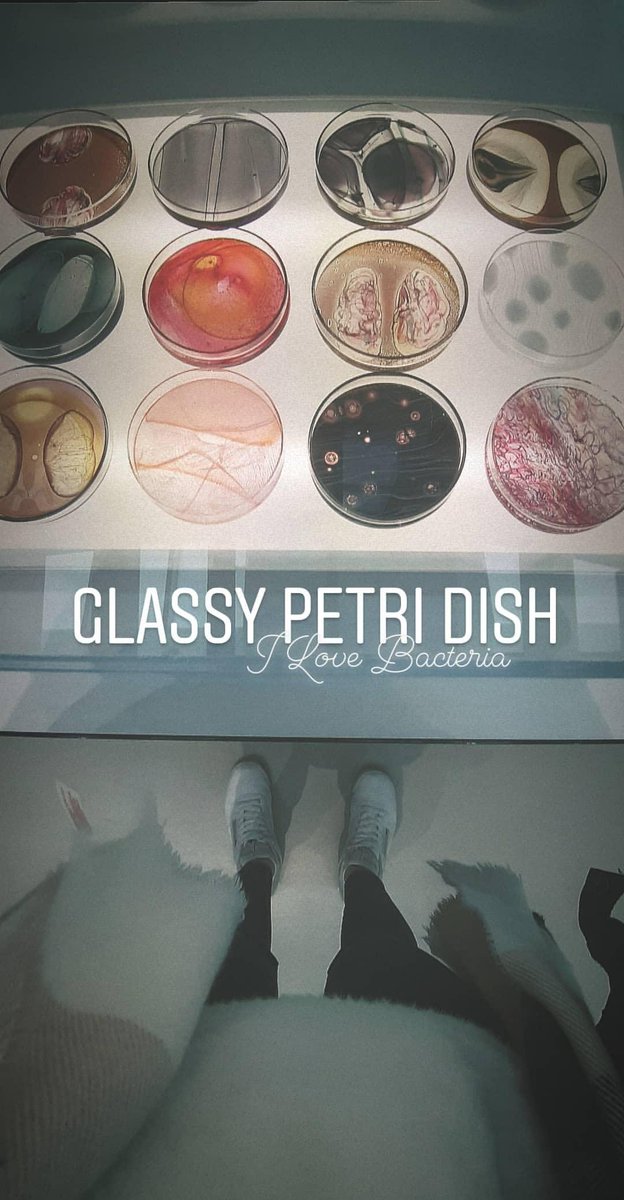
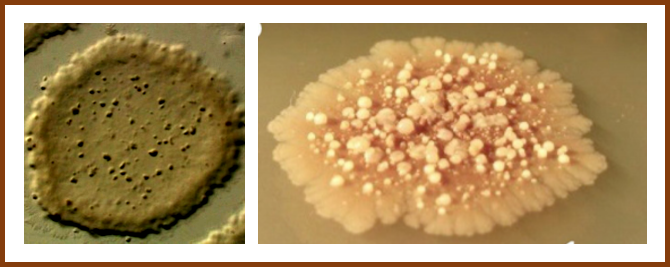

Sigal Ben-Yehuda
@sigalby
Microbiologist
The Hebrew University of Jerusalem, Jerusalem, Israel
twitter.com/HebrewU_heb
ID: 968831185836216321
28-02-2018 12:52:09
27 Tweet
405 Followers
54 Following

















Nanotubes are always cool to look at. But these ones—a first for cyanobacteria—could help scientists better understand the organisms that keep all of us breathing easy. That story and more of the best in Science Magazine and science in #ScienceAdviser: science.org/content/articl…